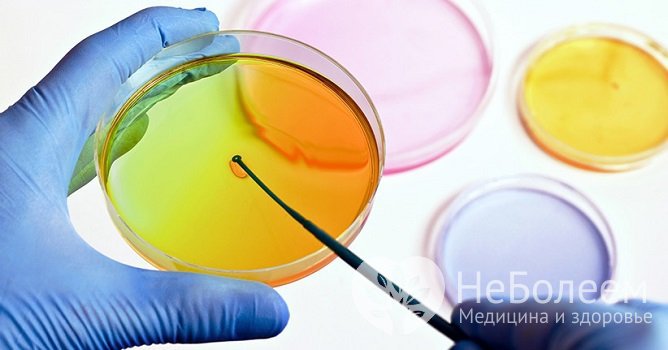
Бакпосев мочи производится на питательные среды, после чего оценивается рост бактерий, их вид и т. д.
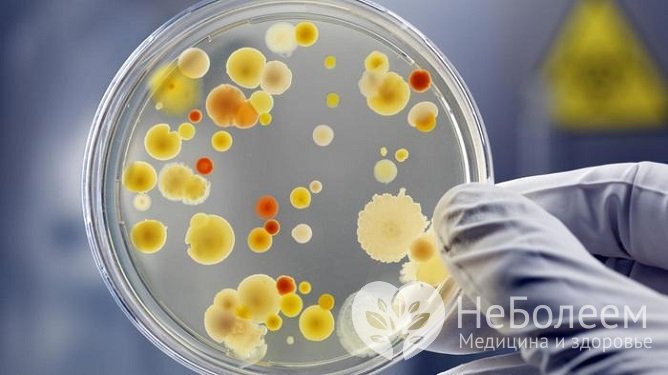
Для острых инфекций характерна монокультура бактерий, для хронических – бактериальные ассоциации

Воспользуйтесь поиском по сайту:
Анализ мочи на бакпосев
Содержание статьи:
Анализ мочи на бакпосев (бактериологическое исследование) используется для обнаружения в моче бактерий, подбора антибактериальных препаратов и контроля лечения инфекционно-воспалительных заболеваний органов малого таза.
Для постановки диагноза обычно используются данные не только бакпосева мочи, но и других исследований, а также учитываются клинические признаки патологии.
Бактерии в моче
Инфекционно-воспалительным процессам в мочевыводящих путях свойственно рецидивирующее течение с высокой вероятностью развития осложнений. Чаще всего поражаются мочеиспускательный канал и мочевой пузырь, нередко инфекция распространяется на мочеточники и почки. Исчезновение клинических признаков острой бактериальной инфекции в мочевыводящих путях нередко говорит не о выздоровлении, а о хронизации процесса, т. е. переходе его в вялотекущую хроническую форму. Воспаление и бактериурия (наличие бактерий в моче) при этом сохраняется, что помогает выявить бакпосев мочи.
Бакпосев мочи производится на питательные среды, после чего оценивается рост бактерий, их вид и т. д.
Бакпосев мочи производится на питательные среды, после чего оценивается рост бактерий, их вид и т. д.В норме в мочевыводящих путях микроорганизмы отсутствуют, исключение составляет только дистальный отдел уретры, который заселен микрофлорой с кожных покровов промежности (у женщин также из вульвы).
95% всех воспалительных заболеваний органов малого таза вызвано микроорганизмами. Возбудителями инфекции мочевыводящих путей обычно являются кишечная палочка (Escherichia coli), клебсиелла пневмонии (Klebsiella pneumoniae), синегнойная палочка (Pseudomonas aeruginosa), цитробактер (Citrobacter), протей мирабилис (Proteus mirabilis), серрация (Serratia). Кроме того, инфекционными агентами становятся стафилококки (S. epidermidis, S. aureus, S. saprophyticus), стрептококки (S. pyogenes), микоплазма (Mycoplasma) и пр. При некомпенсированном сахарном диабете в мочевых путях часто обнаруживаются микроскопические грибы рода Candida.
Инфекциям мочевыводящих путей способствуют патологии, при которых нарушается отток мочи, а также системные заболевания. У детей, лиц преклонного возраста и ослабленных пациентов инфекционный процесс нередко протекает в латентной форме или имеет неспецифические проявления (нарушение пищеварения, потеря веса и пр.).
Для сбора мочи на бакпосев не следует пользоваться стеклянными банками, бытовыми пластиковыми емкостями, нельзя использовать нестерильные одноразовые контейнеры.
Для определения возбудителя проводится бактериальный посев мочи. Направление на исследование обычно выдает терапевт, уролог, акушер-гинеколог. При необходимости врач подробно объяснит, что такое анализ мочи на бакпосев, что показывает данное исследование, как собирать материал, сколько делается тест. Расшифровывать полученный результат должен только специалист.
Показания к анализу
В отличие от клинического анализа мочи, бактериологический анализ не проводится в профилактических целях, а назначается при наличии признаков инфекции мочевыводящих путей. Поводом к назначению бактериального посева мочи может быть обнаружение бактерий или грибов при проведении общего анализа мочи. Кроме того, данное исследование обычно назначается пациентам с рецидивами цистита, паранефритом, пиелонефритом, хроническим уретритом, сахарным диабетом, а также при мониторинге состояния ВИЧ-инфицированных пациентов и пр. Анализ мочи на бакпосев относится к обязательным исследованиям, которые проводятся беременным, в 3–10% случаев определяется бессимптомная бактериурия.
Мочу для бактериологического анализа сдают до начала или через 7–14 дней после завершения антибактериальной терапии (контрольное исследование), если лечащим врачом не указаны другие условия.
Подготовка к анализу мочи на бакпосев
Существует ряд правил подготовки к сдаче мочи для бактериологического исследования, соблюдение которых позволяет получить максимально достоверный результат.
За неделю до анализа из рациона рекомендуется исключить соленую, острую и жирную пищу, а также спиртные напитки.
При острых инфекционно-воспалительных процессах обычно выделяется монокультура на фоне бактериурии высокой степени, а при хронических – ассоциации микроорганизмов на фоне бактериурии низкой степени.
Женщинам не следует сдавать мочу на бакпосев во время менструации и еще двое суток после ее окончания, так как менструальные выделения, которые с высокой вероятностью могут попасть в собранный материал, повлияют на результат исследования. Также за два дня перед исследованием не рекомендуется использовать противозачаточные или лекарственные препараты в форме вагинальных суппозиториев. Перед взятием материала на анализ нельзя делать спринцевание.
Читайте также:
Правила сбора материала для анализа
Перед сбором мочи проводят тщательный туалет наружных половых органов без использования антибактериального мыла. Мужчинам для предотвращения контаминации мочи перед сбором материала рекомендуется тщательно промыть половой член и складку крайней плоти. Для исследования необходимо собрать среднюю порцию первой утренней мочи (то есть начальная и последняя порция спускаются в унитаз). Моча собирается в специальный стерильный одноразовый контейнер, который выдается в лаборатории перед проведением анализа или приобретается в аптеке. В некоторых лабораториях можно приобрести транспортную пробирку с консервантом (обычно с борной кислотой). Набирая мочу, не следует прикасаться к внутренней стенке контейнера.
Материал для бактериологического исследования у грудных детей собирают при помощи мочеприемника, который можно приобрести в аптеке, а потом переливают в стерильный контейнер.
Для сбора мочи на бакпосев не следует пользоваться стеклянными банками, бытовыми пластиковыми емкостями, так как обеспечить стерильность подобной тары в домашних условиях, как правило, не представляется возможным. Кроме того, нельзя использовать нестерильные одноразовые контейнеры.
Доставить в лабораторию материал необходимо не позднее двух часов после сбора.
В норме в мочевыводящих путях микроорганизмы отсутствуют, исключение составляет только дистальный отдел уретры, который заселен микрофлорой с кожных покровов промежности.
Результат анализа
Основной задачей анализа является выявление в моче микроорганизмов и определение их этиологической роли. Во внимание принимается вид инфекционного агента, степень бактериурии, обнаружение микроорганизмов в повторных исследованиях и т. д.
Бактериальный посев мочи производится на питательные среды при помощи бактериологической петли, тампона или шпателя. В норме рост микроорганизмов отсутствует, признаки микробного роста говорят о наличии бактериальной инфекции в моче, т. е. бактериурии.
Степень бактериурии позволяет провести дифференциальную диагностику инфекционного процесса от контаминации урины нормальной микрофлорой. Так, бактериурия до 103 микробных клеток в 1 мл мочи обычно указывает на отсутствие инфекционно-воспалительного процесса и, как правило, определяется в случае контаминации урины, при бактериурии 104 результат является сомнительным и появляется необходимость в повторном исследовании, 105 и более – инфекционно-воспалительный процесс.
Для острых инфекций характерна монокультура бактерий, для хронических – бактериальные ассоциации
Для острых инфекций характерна монокультура бактерий, для хронических – бактериальные ассоциацииС целью контроля проводимой терапии оценивается изменение степени бактериурии, ее уменьшение свидетельствует об эффективности применяемых лекарственных средств. Однако при расшифровке анализа мочи на бакпосев следует учитывать, что в ряде случаев (при проведении антибактериальной терапии, низких значениях pH и/или удельного веса мочи, нарушенном пассаже мочи и пр.) низкая степень бактериурии может определяться и при наличии патологического процесса. По этой причине немаловажное значение имеет также идентификация обнаруженных в моче инфекционных агентов (повторное выделение бактерий одного вида, как правило, указывает на наличие инфекции).
В отличие от клинического анализа мочи, бактериологический анализ не проводится в профилактических целях, а назначается при наличии признаков инфекции мочевыводящих путей.
Диагностическое значение имеет выявление в моче монокультуры или ассоциации микроорганизмов. При острых инфекционно-воспалительных процессах обычно выделяется монокультура на фоне бактериурии высокой степени, а при хронических – ассоциации микроорганизмов на фоне бактериурии низкой степени.
Помимо выявления инфекционного агента при проведении анализа мочи на бакпосев может определяться чувствительность к антибиотикам выделенных штаммов микроорганизмов.
Для постановки диагноза обычно используются данные не только бакпосева мочи, но и других исследований, а также учитываются клинические признаки патологии.
Видео с YouTube по теме статьи:
Об авторе

Нашли ошибку в тексте? Выделите ее и нажмите Ctrl + Enter.
По статистике, по понедельникам риск получения травм спины увеличивается на 25%, а риск сердечного приступа – на 33%. Будьте осторожны.
























